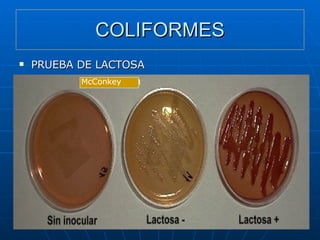
COLIFORMES PRUEBA DE LACTOSA McConkey

Los coliformes son un grupo de bacterias que incluyen a Escherichia coli, la cual fue aislada por primera vez en 1860. Los coliformes se encuentran en el intestino de humanos y animales de sangre caliente y son indicadores de contaminación fecal en aguas. E. coli es el único microorganismo cuya presencia indica con certeza contaminación fecal, aunque también puede encontrarse en el ambiente sin origen fecal. Los coliformes totales y fecales se usan como indicadores de calidad en alimentos.